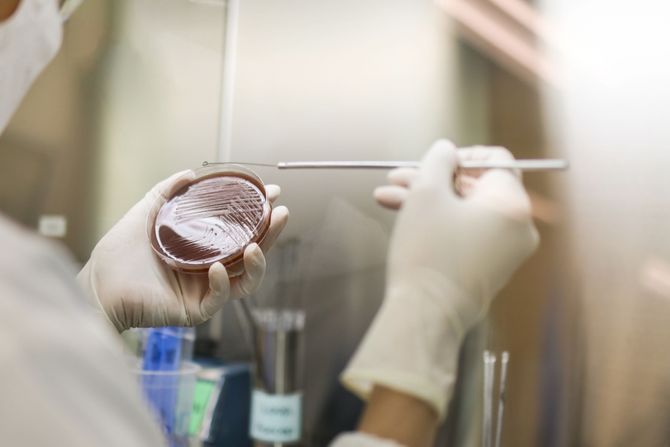
infekcije, testiranje

Da stid ne ugrozi zdravlje, testirajte se na polno prenosive bolesti jednom godišnje, ili i češće
Seksualno aktivne osobe treba redovno da se testiraju na polno prenosive infekcije (PPI). Preporuka lekara jeste da se testiranje obavi jednom godišnje, ili i češće (na svakih šest meseci) ako osoba ima više partnera, ne koristi redovno kondom ili oseti tegobe koje mogu da budu simptomi PPI. Pravilan izbor testova je veoma važan, poželjno je obaviti razgovor sa lekarom ili savetnikom za PPI. Na izbor načina testiranja utiču brojni faktori: vreme proteklo od rizičnog kontakta, vrsta rizika, prethodne infekcije, pridružene bolesti.
Serološko testiranje
Gradski zavod za javno zdravlje Beograd navodi da je serološko testiranje najčešća screening metoda, koja može da otkrije moguću infekciju 3 do 8 nedelja od rizičnog kontakta. Ovaj period, poznat je kao „prozor period“, u zavisnosti od patogena, različito traje i treba ga imati u vidu prilikom izbora testa i tumačenja rezultata.
Brzi testovi predstavljaju screening metod, a pošto se rade iz kapilarne krvi, najčešće se koriste van zdravstvenih ustanova (teren, savetovališta, samotestiranje). Oni mogu sa visokom pouzdanošću da pokažu da li je došlo do infekcije, ako se primenjuju nakon isteka „prozor perioda“, koji je obično nešto duži nego kod testova iz vene.
Molekularna dijagnostika
Molekularna dijagnostika značajno je skratila prozor period, jer detektuje sam patogen (čak i u vrlo malom broju), a ne antitela. To su, sada već svima poznati posle pandemije COVID-19, PCR testovi. Ovi testovi imaju primarnu ulogu u potvrdnoj dijagnostici infekcija HIV-om, hepatitisima B i C , a ređe se koriste kao screening metoda u ranoj fazi infekcije. Takođe su važni u praćenju efikasnosti lečenja i utvrđivanju porekla infekcije.
PCR testovi su postali metoda izbora za dijagnostiku infekcija HPV-om, gonokokom, hlamidijom i ureaplazmom.
Rizici seksualnog ponašanja
Nivo rizika zavisi od više faktora: broja partnera, seksualne istorije partnera, vrste seksualnih aktivnosti (vaginalni/analni/oralni seks), nepoznatog statusa partnera, istorije prethodnih PPI, upotrebe psihoaktivnih supstanci koje olakšavaju rizično ponašanje i prisustva drugih anogenitalnih promena.
Kondom i smanjenje broja partnera značajno umanjuju rizik, ali ne štite u potpunosti od svih infekcija (npr. HPV, herpes). Stigma i prepreke u pristupu zdravstvenoj zaštiti dodatno povećavaju rizik jer osobu mogu odvratiti od blagovremenog testiranja, upozoravaju stručnjaci Gradskog zavoda za javno zdravlje Beograd.
Komplikacije polno prenosivih infekcija
Nelečene PPI mogu da dovedu do ozbiljnih individualnih i javno-zdravstvenih posledica:
- reproduktivne komplikacije kao što su upalna bolest karlice (PID), neplodnost i vanmaterična trudnoća, česta su posledica nelečene hlamidije ili gonoreje
- sistemske komplikacije, uključujući neurosifilis ili kardiovaskularne manifestacije sifilisa
- prenošenje infekcije na partnere i novorođenče
- povećan rizik sticanja ili prenošenja HIV-a kod osoba sa nelečenim bakterijskim ili ulcerativnim PPI
- socijalne i psihološke posledice
Rano otkrivanje, pravilno lečenje i obaveštavanje partnera imaju ključnu ulogu u prevenciji i sprečavanju komplikacija.
U Gradskom zavodu za javno zdravlje Beograd moguće je uraditi testiranje na brojne PPI iz krvi ili briseva (uretra ili grlić materice). Imajući u vidu visoku cenu PCR dijagnostike u privatnom sektoru, važno je istaći da se ova dijagnostika može obaviti uz uput izabranog lekara/ginekologa, bez doplate za sve kojima je potrebna. Savetovalište za HIV i PPI dostupno je za dodatne informacije i otklanjanje nedoumica.
(eKlinika)
eKlinika zadržava sva prava nad sadržajem. Za preuzimanje sadržaja pogledajte uputstva na stranici Uslovi korišćenja.


